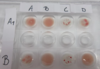

Blodgruppscerologi Flashcards
(16 cards)
När kan det vara viktigt att ha koll på sina blodgrupperingar?
- Blodtransfusion
- Graviditetsimmunisering
- Viktigt för att mamman inte ska utveckla antikroppar mot fostrets antigen (RhD)
- Organtransplantation
- AB0- viktigt vid transplantation av hjärta, lever, njurar och lungor
Vad kan de eventuella anitkropparna göra mot blodgruppen?
- Binda till erytrocyterna och orsaka hemolys
Vad innebär reguljära antikroppar?
- Sådana som regelmässigt finns mot de antigen som man själv saknar
- Finns bara inom ABO-systemet
- Ex en person med A uttrycker alltid anti-B-antikroppar
Vad innebär irreguljära antikroppar?
- Sådana som (kan ha) bildats efter exponering för antigen man själv saknar
- Sker inte regelmässigt, en person som är RhD-negativ uttrycker inte alltid RhD-antikroppar men kan utveckla dessa vid exponering
Vad innebär Landsteiners regel?
Man har alltid antikroppar mot det/de antigen man själv saknar inom AB0-systemet

Vad ska vi tänka på vid erytrocyttransfusion?
Vad händer om vi ger fel?

- Vid erytrocyttranfusion tillförs antigen
- Hänsyn måste tas till mottagarens antikroppar, risk för fatal hemolytisk transfusionsreaktion om det blir fel
- O till alla
- Reguljära antikroppar av IgM-typ, kapabla att binda in till komplementsystemet intravaskulärt efter att de bundit antigenet vilket ger den intravaskulära hemolysen

Vad ska vi tänka på vid plasmatransfusion?
Plasmatransfusion
- Vid plasmatransfusion tillförs antikroppar
- Hänsyn måste tas till mottagarens erytrocytantigen
- AB till alla

Vad är viktigt att veta gällande RhD?
Av vilken typ är antikropparna?
- Har man RhD är man RhD-positiv
- Saknar man RhD är man RhD-negativ
- RhD har en mkt hög antigenicitet, dvs ger ofta upphov till antikroppsbildning om en individ som saknar RhD kommer i kontakt med erytrocyter som har RhD
- Graviditet (modern RhD- och fostret RhD+, liten del av fostrets blod kan passera placenta och ge upphov till antikroppar, vid första graviditeten sker ingenting men vid nästa graviditet kan dessa antikroppar (av IgG-typ) passera placenta och orsaka hemolys i fostret
- Transfusion
- Hos individ som bildat anti-D ger transfusion av RhD-positivt blod upphov till transfusionsreaktion (extravasal hemolys)
- Anti-D är vanlig orsak till HDN (hemolytic disease oft the newborn)
- Rh-profylax kan ges för att förhindra uppkomst av anti-D
När gör vi mödravårdsscreening gällande blodgrupper?
- Blodgruppering inklusive antikroppsscreening i v. 10 på alla kvinnor (även andra antikroppar som anti-KEL)
- RhD neg. kvinnor typas dessutom på fetalt RhD
- Ny antikroppsscreen v. 29
- RhD-negativa kvinnor som bär ett RhD-positivt barn (enl provtagning v. 10) ges RhD-profylax förebyggande redan under graviditet
- Om irreguljär antikropp av betydelse för det väntande barnet hittas hos moder, följs mamman med regelbunden provtagning resten av graviditet (om de stiger eller fostret påverkas)
Antikroppars kliniska relevans
- Immunogenecitet (vissa antigener ger inte utveckling av antikropp), RhD räcker med mkt liten mängd
Vilken klass ger i regel svårast reaktioner?
IgG
Direkt antiglobulintest (DAT)
- Visar om patintens erytrocyter är mantlade med antikroppar och/eller komplement in vivo
Vilka indikationer har v för detta test?
- Autoimmun hemolytisk anemi (autoantikroppar mot sina egna erytrocytantigener), testet visar helt enkelt att erytrocyterna är coatade (mantlade) med antikroppar
- Hemolytisk transfusionreaktion (vi kan diagnostisera om pat. fått fel blodgrupp vid transfusion)
- Graviditetsimmunisering (positiv DAT från navelsträng talar för att det finns antikroppar bundna till fostrets erytrocyters RhD
Vilka rutiner är viktiga vid provtagning utöver
- Vikten av att försäkra sig om mottagarens fullständiga identitetsuppgifter
- Svenskt personnummer (alternativt tillfälligt personnummer)
- Spårbara uppgifter
- För och efternamn
- Nyfödda barn, mammans identitet och om barnet saknar personnummer ska barnets BB-nummer anges
?
- Blodprov för blodgruppsbestämning och förenlighetsprövning ska tas från mottagaren vid två separata tillfällen (utom i extrema fall)
- Ex blodgruppsbestämning på mottagning och förenlighetsprövning på operationsdag
ABO-gruppering
- Blodprov från patienten separeras vilket ger oss plasma i ett rör och erytrocyter (späds) i ett annat
- Vi använder Viggoplatta för antigengruppering och plasmagruppering
- Raderna under A-D består av erytrocyter, regaens består av serum (AB ska inte ge reaktion och fungera då som negativ kontroll)
- Först tillsätts serum och sedan erytrocyter från patienten
- Blanda genom rotation i 15 min
- Agglutinat (ihopklumpning av erytrocyter)à positiv reaktion
- Gradera reaktion 0-4 (2-4 ses med ögat), ju mer kompakt desto högre grad, grad 4 är en enda klump
- Negativ reaktion = 0
Tolkning?

- Patient A = A (4+)
- Patient B = AB (4+, 3+)
- Patient C = 0
- Patient D = B (3+)

Plasmagruppering
- Till skillnad så tillsätter vi patientens plasma i varje brunn
- I A1 tillsätts erytrocyter av blodgrupp A
- Reaktion tyder på antikroppar förstås
- Blanda genom rotation i 15 min
- Läses av på samma sätt som ovan
Tolkning?
- Patient A = A (2+)
- Patient B = AB
- Patient C = 0 (3+, 3+)
- Patient D = B (2+)

RhD-gruppering
- Erytrocyter från patienten i bägge rören (K = kontroll)
- Anti-D tillsätts rör A och vid positivt resultat (innehåller RhD+) sker agglutination
- Rh-Hr-kontroll i rör märkt K, innehåller inget Anti-D
- Centrifugera 3-5 min och vagga lätt.
- Gradera agglutination enligt samma princip 0-4 (röret 4+)
Hur många % är RhD-?

15 %
Vad innebär blodgruppering och förenlighetsprövning?
Blodgruppering
- ABO-bestämning
- RhD-bestämning
- Antikroppsscreening
Förenlighetsprövning
- BAS-test (Blodgruppskontroll och AntikroppsScreening)
- MG-test (Plasma undersöks mot varje beställd blodenhet på förekomst av antikroppar riktade mot andra blodgruppssystem än ABO-systemet)


